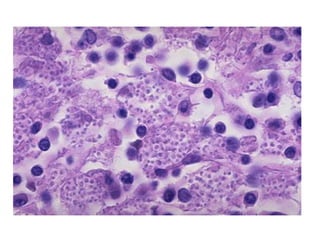
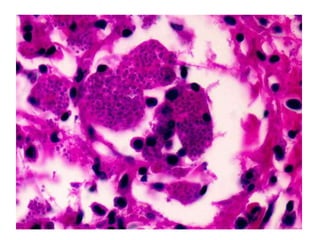

This document discusses fungal infections in histopathology. It provides advantages of histopathology for fungal identification, describes special staining techniques used to identify fungi in different tissues, outlines major fungal forms seen, and lists true and opportunistic fungal pathogens. It also describes 8 cases presenting with fungal infections and provides the diagnoses for each case. The document serves as a reference for histopathologists to identify fungi in tissue samples.